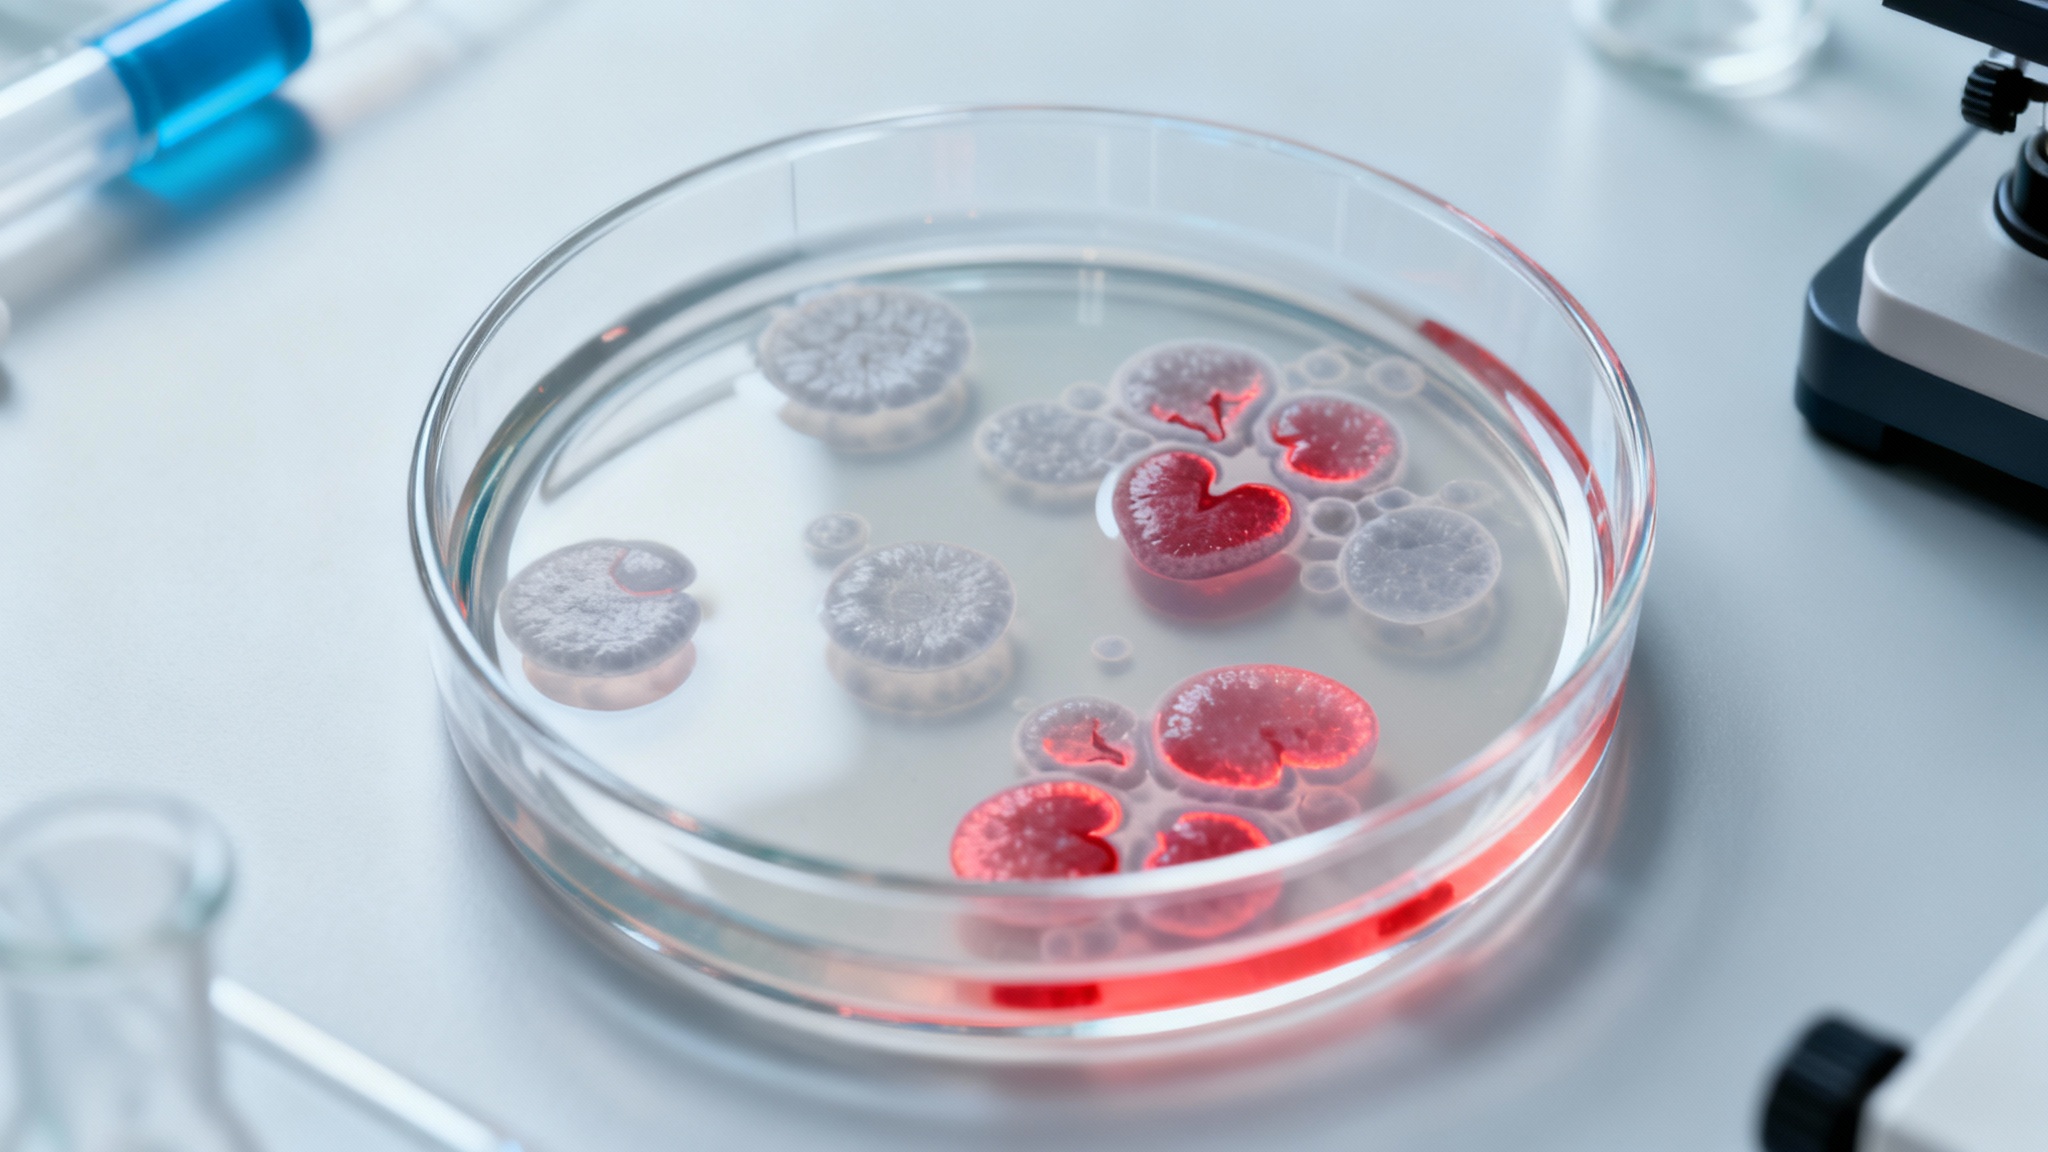
La science pourrait-elle un jour réparer nos cœurs brisés par la maladie ?

Le constat d'un cœur qui cicatrise mais ne guérit pas

La piste fœtale : une mémoire cellulaire endormie

Des cellules humaines se remettent à proliférer en laboratoire

Plus qu'une simple multiplication, une régénération fonctionnelle

Conclusion : une nouvelle stratégie pour la médecine de demain ?

Selon la source : trustmyscience.com

